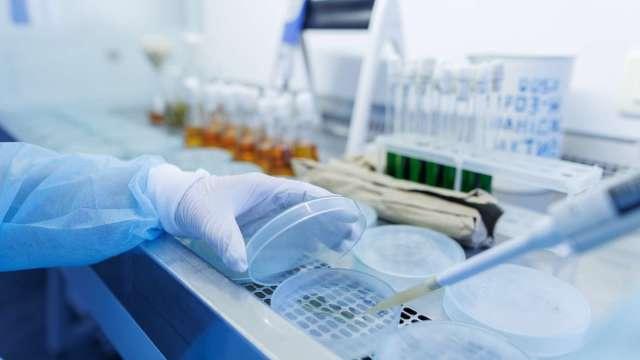

鉅亨網新聞中心 2025-06-06 19:34
在全球環境污染日益嚴峻的挑戰下,工業廢水、石油污染等問題威脅著生態安全與人類健康。特別是高鹽環境下的複雜有機污染物,因其毒性強、難以生物降解,傳統的微生物修復方法往往受限於對鹽脅迫的耐受性不足,難以有效處理。
 超級工程菌問世:中國團隊破解高鹽有毒廢水治理難題(圖:shutterstock)
超級工程菌問世:中國團隊破解高鹽有毒廢水治理難題(圖:shutterstock)
上海交通大學團隊在《自然》期刊發表的研究顯示,其利用海洋細菌需鈉弧菌 (Vibrio natriegens) 構建的「超級工程菌」,在高鹽有毒廢水治理中展現出驚人能力,為全球污染治理提供了中國方案。
海洋細菌需鈉弧菌是一種天然具備優異耐高鹽特性 (能在鹽度高達 10% 的環境中存活,超過海水鹽度 3 倍) 且生長速度極快的微生物。
研究團隊利用合成生物學策略,將來源於不同菌種的 5 個降解基因簇 (總長 43kb) 透過其開發的 INTiMATE(迭代自然轉化) 基因組工程方法,穩定整合到需鈉弧菌 Vmax 菌株的基因組中,構建出全球首株能同時高效降解多種劇毒污染物的「超級工程菌」—— VCOD-15。
這種工程菌株 VCOD-15 在實際應用測試中展現出驚人能力。它能夠同時降解聯苯、苯酚、萘、二苯並呋喃和甲苯這五種複雜有機污染物。在來自氯鹼廠和煉油廠的高鹽工業廢水樣本中,VCOD-15 的污染物去除效率顯著優於天然降解菌。實驗數據顯示,在 48 小時內,其對聯苯的降解率達 100%,甲苯清除率近 90%,二苯並呋喃降解率達 89.3%。在鹽漬土壤中也顯示出有效的淨降解率。

這項技術可廣泛應用於石油煉化、化工製藥等全球性工業領域排放的高鹽廢水處理,以及海洋生態修復。
據估算,僅中國工業廢水處理市場規模已超萬億,而 VCOD-15 的「零耗能、零添加、高效率」 特性,將大幅降低傳統物理化學處理的高昂成本(如活性炭吸附成本約
人民幣 2000 元 / 噸),推動環保產業向綠色低碳轉型。